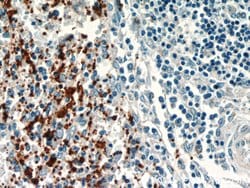
CD41/Integrin alpha 2b Rabbit anti-Human, Mouse, Rat, Polyclonal, Proteintech

missing translation for 'onlineSavingsMsg'
Learn More
Learn More
CD41/Integrin alpha 2b Rabbit anti-Human, Mouse, Rat, Polyclonal, Proteintech
Rabbit Polyclonal Antibody
Brand: Proteintech 24552-1-AP-20UL
This item is not returnable.
View return policy
Description
CD41 (platelet glycoprotein IIb, ITGA2B) is composed of two subunits -120 kDa a, alpha and 23 kDa b, beta- that interact with CD61 in the presence of calcium to form a functional adhesive protein receptor. CD41 is also involved in blood coagulation by mediating platelet aggregation. Upon blood vessel damage, CD41 binds to a variety of proteins including von Willebrand factor, fibrinogen, fibronectin and vitronectin. CD41 is mainly expressed on megakaryocyte-platelet lineage, but generally belongs to the antigens that are expressed during the early stages of hematopoietic differentiation. Diseases associated with CD41 dysfunction include Glansmann Thrombasthenia, and Platelet type-16 bleeding disorder.Specifications
| CD41/Integrin alpha 2b | |
| Polyclonal | |
| Unconjugated | |
| ITGA2B | |
| CD41, CD41B, GP2B, GPalpha IIb, GPIIb, GTA, HPA3, Integrin alpha IIb, ITGA2B, ITGAB | |
| Rabbit | |
| Antigen Affinity Chromatography | |
| RUO | |
| 16399, 3674, 685269 | |
| -20°C | |
| Liquid |
| Western Blot, Immunohistochemistry (Paraffin), Immunoprecipitation | |
| 0.45 mg/mL | |
| PBS with 50% glycerol and 0.1% sodium azide; pH 7.3 | |
| P08514, Q9QUM0 | |
| Itga2b | |
| CD41/Integrin alpha 2b Fusion Protein Ag19459 | |
| 20 μL | |
| Primary | |
| Rat, Human, Mouse | |
| Antibody | |
| IgG |
Product Content Correction
Your input is important to us. Please complete this form to provide feedback related to the content on this product.
Product Title
Spot an opportunity for improvement?Share a Content Correction